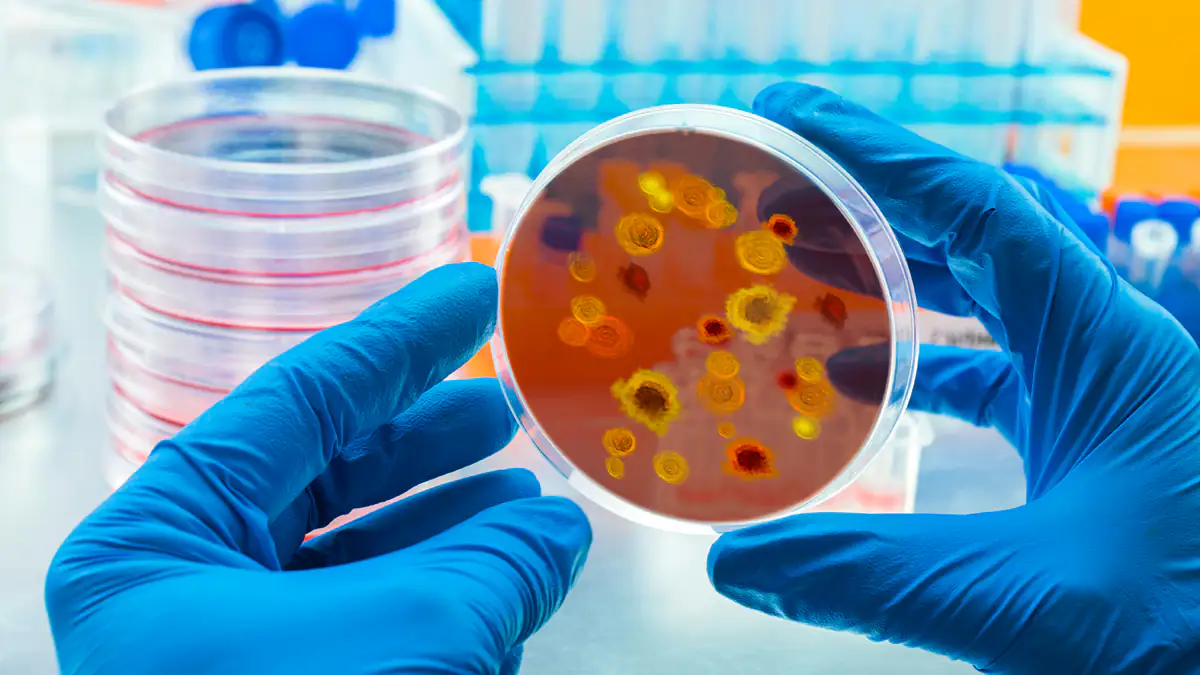
RKI warnt: Dengue-Fieber breitet sich in Deutschland aus

Weltweit breitet sich das Dengue-Fieber immer stärker aus. Auch Deutschland ist von zahlreichen Krankheitsfällen betroffen. Ursprünglich kam das Virus hauptsächlich in den Tropen vor. Mittlerweile bleibt aber auch Südeuropa von größeren Ausbrüchen der Infektionskrankheit nicht mehr verschont.
Das Robert-Koch-Institut warnt nun vor der Infektionsgefahr in Deutschland. "In den ersten 17 Wochen des Jahres 2024 wurden bislang 737 Denguefieber-Fälle (...) übermittelt. Dies sind 324 Prozent mehr als im gleichen Zeitraum im Vorjahr (174 Fälle)." Auch einen Todesfall hat es hierzulande gegeben. Weltweit werden jährlich rund 390 Millionen Fälle des Dengue-Fiebers registriert.

Diese Symptome löst das Dengue-Fieber aus
Auch in Europa treten die Fälle immer häufiger in Regionen auf, in denen das Virus bisher gar nicht vorgekommen ist. Dazu führt aber keinesfalls die erhöhte Reiseaktivität der Bürger. Stattdessen hängen die Ausbrüche mit der Asiatischen Tigermücke zusammen. Aufgrund des Klimawandels ist sie mittlerweile auch verstärkt in Europa zu Hause. Italien ist ganz besonders stark betroffen.
Ungefähr jeder Vierte, der sich infiziert, zeigt Symptome. Zumeist verläuft die Erkrankung harmlos und die Symptome klingen folgenlos wieder ab. Bei rund ein bis fünf Prozent kommt es zu schweren Verläufen oder sogar Todesfällen. Zu den Beschwerden zählen Schüttelfrost und Fieber sowie Kopf-, Muskel-, Glieder- oder Knochenschmerzen. Schlimmstenfalls können Komplikationen wie innere Blutungen und eine Schockreaktion auftreten. Deshalb sollte man sich mit geeigneten Sprays gründlich gegen Mückenstiche schützen. Zudem ist in einigen Ländern mittlerweile ein Impfstoff verfügbar.